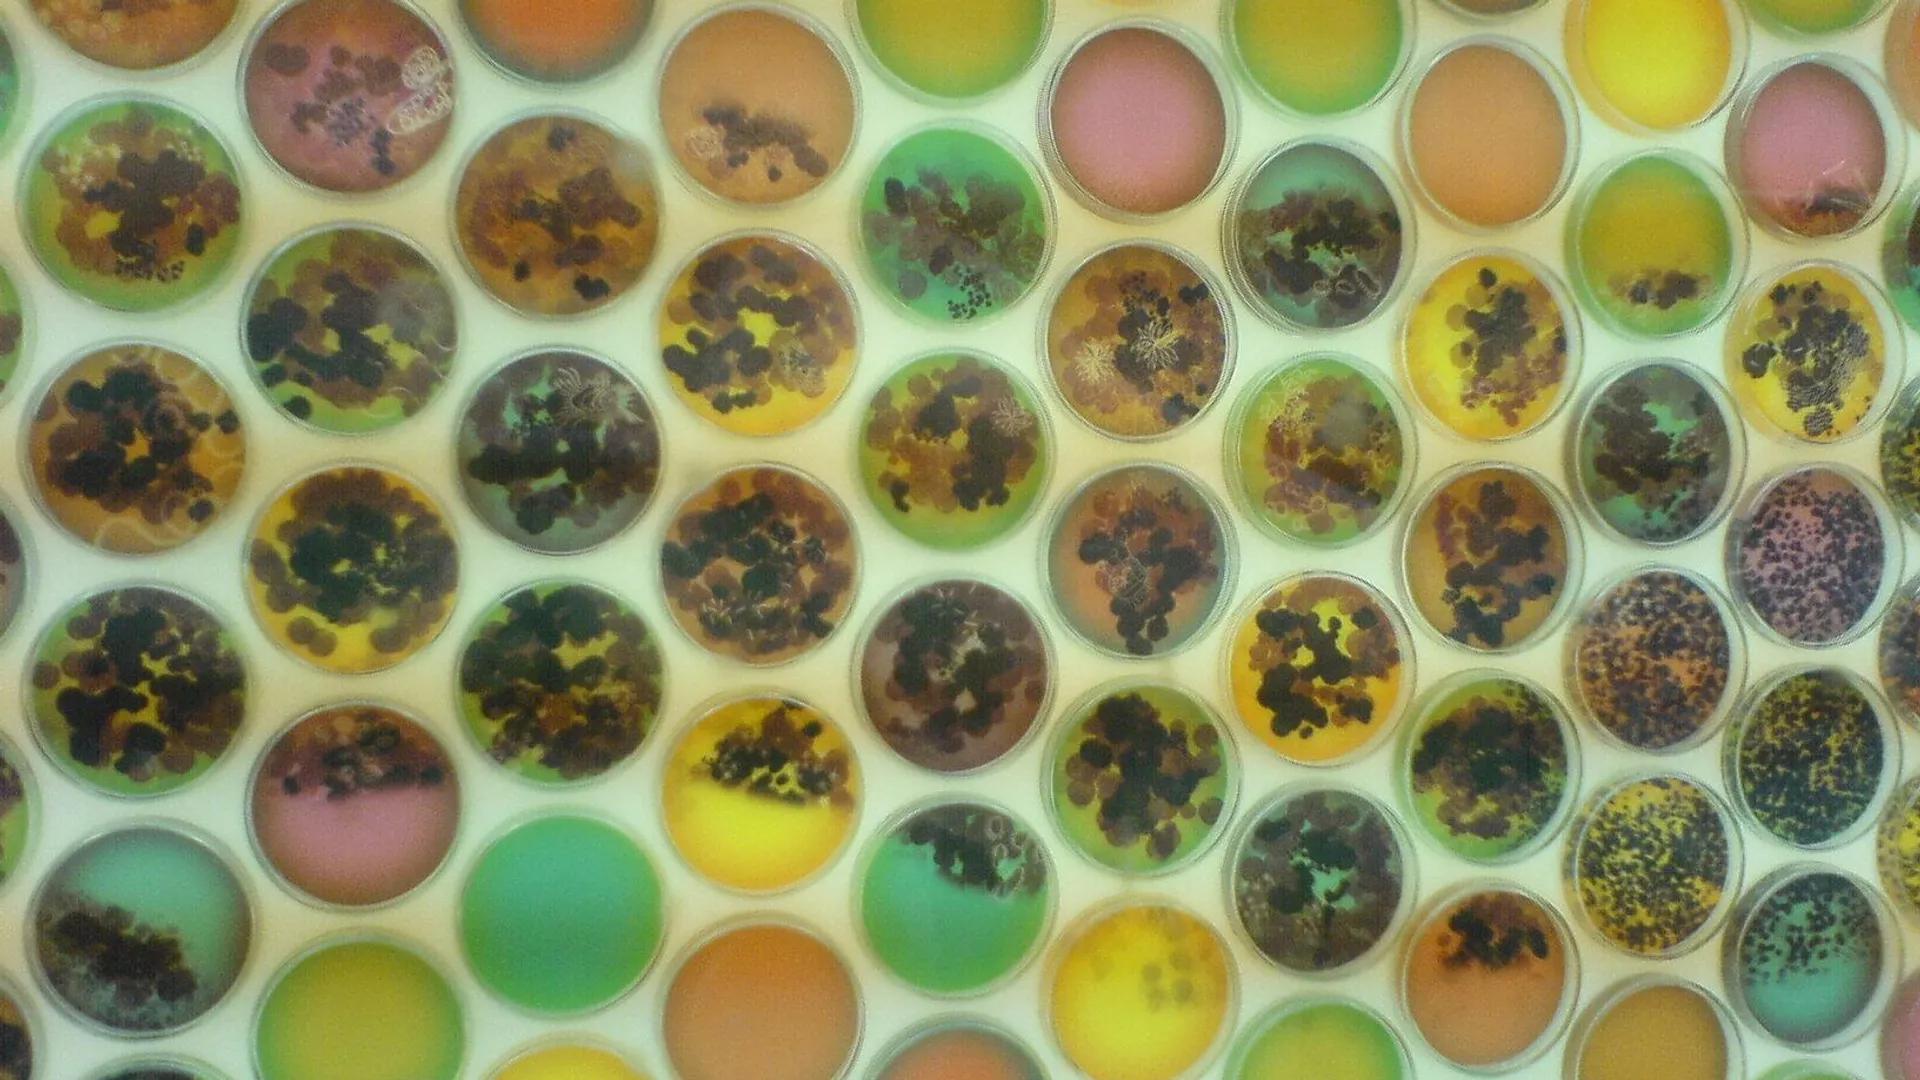

Africa-Press – Cape verde. Coating technology for various tissues enables scientists to produce a material that prevents the growth of bacteria and fungi, while also being resistant to nosocomial infections.
A startup from Saint Petersburg State University of Industrial Technologies and Design has developed new technology with possible applications in medicine and light industry.
The materials reportedly reduce bacteria by 99.9% in less than 24 hours, including strains that cause infections against which there are no current means of protection.
The material coating technology was carried out within the “Platform for University Technological Entrepreneurship” federal project acceleration program.
Its development is based on the technology of the chemical synthesis of bimetallic nanoparticles in the material structure. “The modified materials have a strong fungicidal and bactericidal effect,” project leader Ekaterina Kudryavtseva noted.
According to her, the development will be of interest primarily to light industry and medical organizations, since the treatment of medical coats will cost no more than 300 rubles ($4-5), and the effect remains after 25 washings.
At the same time, the developers pointed out that copper and silver reinforce each other’s effect, making the bactericidal and fungicidal properties of such materials more potent compared to their analogs.
“Protective properties against dangerous strains of microorganisms, including Acenobacter, Pseudomonas aeruginosa, Staphylococcus aureus, Escherichia coli, Enterococcus, Klebsiella, have already been proven,” the NTI concluded.
For More News And Analysis About Cape verde Follow Africa-Press